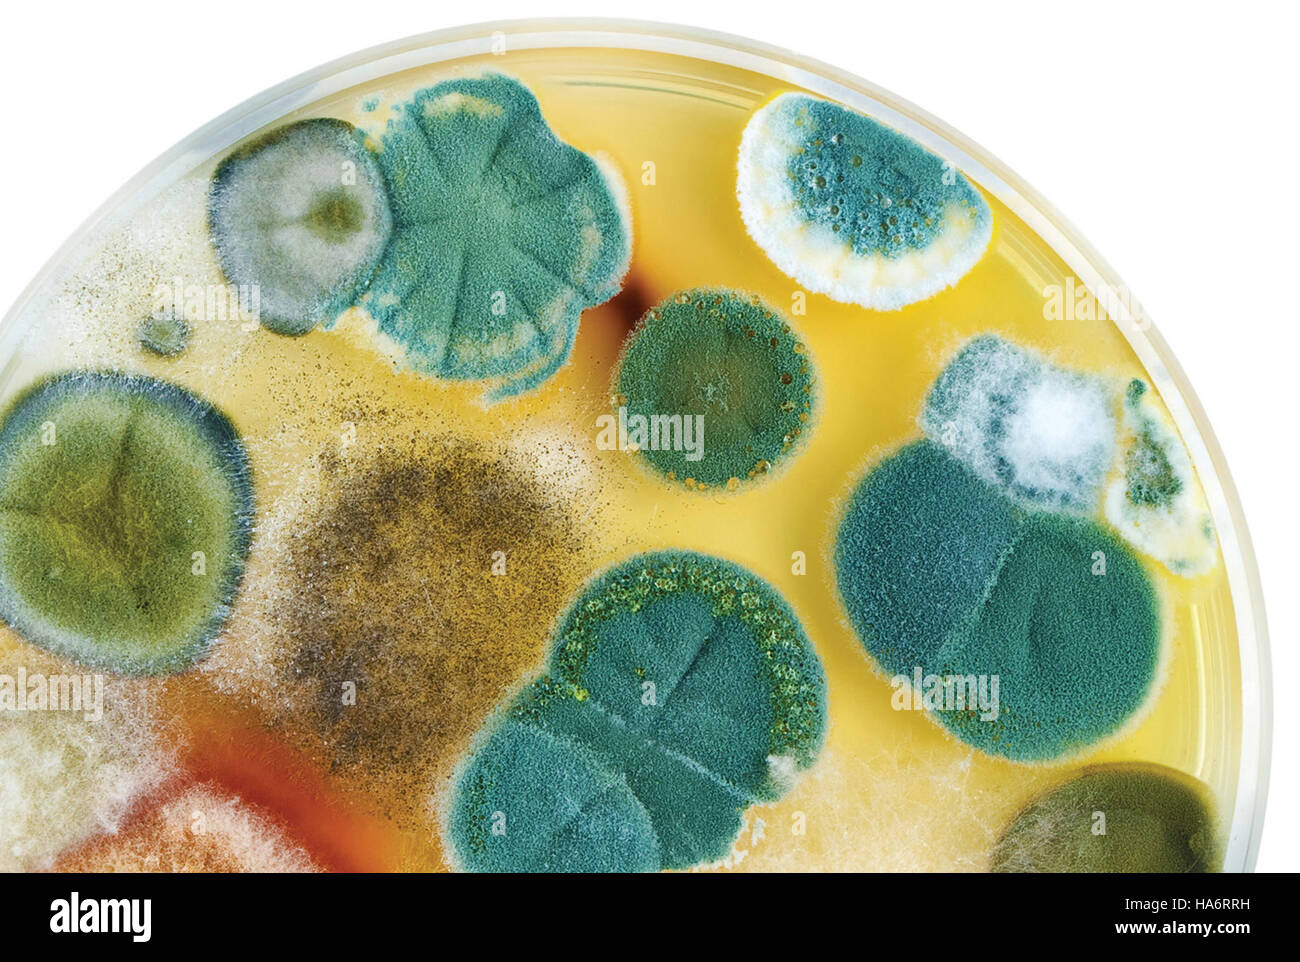

Tecnologia nucleare Immagini Stock
(85,378)Filtri rapidi:
Tecnologia nucleare Immagini Stock

RMKT5C5R–L'Oak Ridge Production and Research Plant, situato nel Tennessee, è rinomato per il suo ruolo significativo nello sviluppo della tecnologia nucleare e della ricerca durante la metà del XX secolo.

RMHA6RXX–Una vista aerea del Los Alamos National Laboratory, un importante sito per la ricerca scientifica e lo sviluppo della tecnologia nucleare negli Stati Uniti.

RM2AW33RG–Mostra di commercio russo alla RAI di Amsterdam Presentazione della tecnologia russa Data: 24 maggio 1972 luogo: Amsterdam, Noord-Holland Parole Chiave: Borse, economia, commercio, relazioni internazionali , energia nucleare, ritratti Istituto Nome: Rai

RM2WWER78–Documentazione sullo sviluppo della ricerca atomica e della tecnologia nucleare da parte della Gran Bretagna, evidenziando i progressi scientifici e militari nel corso del XX secolo.

RMDB8F4Y–Energia,energia nucleare,centro di ricerca nucleare Rossendorf vicino Dresda,sistema a doppia porta,area di accesso con avviso,reattore di ricerca del tipo WWR-S,attivato nel 1957,commutato di più tardi nel 1990,Germania Est,Maggio 1990,incidente,incidenti,ingresso vietato,personale,staff,staff,staff,staff members,ingegneria nucleare,tecnologia nucleare,impianto nucleare,reattore sperimentale,scienze nucleari,non-1990,sicurezza nucleare,sicurezza nucleare-1990,sicurezza nucleare,sicurezza nucleare-1990,sicurezza nucleare-1990,sicurezza nucleare,sicurezza nucleare-1990,sicurezza nucleare aggiuntiva,energia nucleare,energia nucleare-1990-1990

RF2E8WAEM–Persona che tiene il telefono cellulare con il logo della società di tecnologia nucleare China National Nuclear Corporation (CNNC) in esposizione. Mettere a fuoco lo schermo del telefono.

RMMY42M2–. Inglese: il reattore sperimentale in Università Tsinghua. 中文: 清华大学实验反应堆 . 1960. Tsinghua University 173 Reattore sperimentale, Tsinghua University, 1960

RF2A79D58–Energia di atomo di simbolo sul palazzo di vetro. In mirroring e sky city sulla facciata moderna. La scienza, la tecnologia e l'industria nucleare concetto di centro 3D renderi

RM2JRARK9–Ex centrale nucleare sperimentale del Lago di Brasimone (Bologna, Italia), attualmente convertita dall'ENEA (Agenzia Nazionale per le nuove tecnologie, energia e atmosfera) in un centro di ricerca per lo sviluppo di tecnologie di fusione termonucleare controllata, l'innovazione dei sistemi nucleari e il monitoraggio ambientale.

RF3CYKF3T–La centrale nucleare di Rooppur è il primo progetto di energia nucleare del Bangladesh, costruito per soddisfare la crescente domanda di energia elettrica della nazione in modo sostenibile.

RFKX4B5T–Blu brillante tecnologia nucleare design, generato dal computer sfondo astratto, rendering 3D

RME0XEEK–Lug. 07, 1966 - L'Istituto di Chimica Radio: di Monaco di Baviera, Politecnico - Direttore: Prof. Il dott. Hans-Joachim Nato - è ora pronto per essere impostato per funzionare. L istituto è la Germania più importante collegio per quella particolare ramo della scienza. Si tratta di lavorare in stretta collaborazione con Monaco di Baviera atom-reattore. Chimica Radio sta diventando sempre più importante per lo sviluppo della ricerca nucleare e la tecnologia nucleare

RMT5M004–Pechino, Cina. Xvii Apr, 2019. I giornalisti di visitare la Cina Istituto di energia atomica (CIAE) della China National Nuclear Corporation Xinzhen nella città di Pechino, capitale della Cina, 17 aprile 2019. CIAE è il luogo di nascita di della Cina di tecnologia nucleare. Credito: Cai Yang/Xinhua/Alamy Live News

RMKT0CA3–Questa immagine o riferimento riguarda probabilmente la guerra atomica o l'energia atomica, che fu un argomento significativo durante la metà del XX secolo a causa della guerra fredda in corso e dello sviluppo della tecnologia nucleare.

RMHA6T0M–Uno scienziato del Los Alamos National Laboratory esamina i nastri per l'uniformità, un compito cruciale nella ricerca scientifica relativa alla fisica e alla tecnologia nucleare.

RM2AWA0X4–Udienza della Camera inferiore sul reattore di allevatore Kalkar Links J. Benecke (Forschung Gruppe Schneller Brüter), destra Dr. A. von Bülow (ex Ministro per la Ricerca e la tecnologia in Occidente. Germania) Data: 14 Settembre 1983 Luogo: L'Aia, Sud Olanda Parole Chiave: Esperti, Audizioni, Reattori Nucleari Nome Persona: Benecke, Jochen, Bülow Andreas Von Institution Nome: Lower House

RM2K5F1TN–La conferenza NETS 2022 della NASA al Westin Cleveland Downtown si è concentrata sullo sviluppo della tecnologia nucleare per lo spazio. I partecipanti includevano amministratori e ingegneri della Space Technology Mission Directorate che esaminavano i sistemi e le applicazioni emergenti.

RMFGT20F–Pedagogia, università, Università tecnica di Dresda, costruzione della facoltà di tecnologia nucleare, vista esterna, 27.9.1961, diritti aggiuntivi-clearences-non disponibili

RF2E8WAEB–Vista ad alto angolo della persona che tiene uno smartphone con il logo della China National Nuclear Corporation (CNNC) in esposizione con il sito Web. Mettere a fuoco lo schermo del telefono.

RMWJPGHP–Connecticut USA, Aug 2019 - giovani nuotano nel Long Island Sound, utilizzata per raffreddare le aste di dominio macina reattori nucleari, vedere maggiori informazioni

RF2A79D9R–Energia di atomo di simbolo sul palazzo di vetro. In mirroring e sky city sulla facciata moderna. La scienza, la tecnologia e l'industria nucleare concetto di centro 3D renderi

RM2JRARK4–Ex centrale nucleare sperimentale del Lago di Brasimone (Bologna, Italia), attualmente convertita dall'ENEA (Agenzia Nazionale per le nuove tecnologie, energia e atmosfera) in un centro di ricerca per lo sviluppo di tecnologie di fusione termonucleare controllata, l'innovazione dei sistemi nucleari e il monitoraggio ambientale.

RF3CYKCHB–La centrale nucleare di Rooppur è il primo progetto di energia nucleare del Bangladesh, costruito per soddisfare la crescente domanda di energia elettrica della nazione in modo sostenibile.

RF2H1YH7P–Mano gira i dadi e cambia la parola tedesca 'Atomausstieg' (arresto di energia atomica) in 'Atomeinstieg' (ingresso di enegria atomica).

RME0XF3T–Lug. 21, 1966 - L'Istituto di Chimica Radio di Monaco di Baviera, Politecnico - direttore: POF. Il dott. Hans-Joachim Nato - è ora pronto per essere impostato per funzionare. L istituto è la Germania più importante collegio per quella particolare ramo della scienza. Si tratta di lavorare in stretta collaborazione con Monaco di Baviera atom-reattore. Chimica Radio sta diventando sempre più importante per lo sviluppo della ricerca nucleare e della tecnologia nucleare. Dati dell Istituto di Chimica Radio di Monaco di Baviera La foto mostra il dr.

RMT5KYWK–(190425) -- Pechino, 25 aprile 2019 (Xinhua) -- i giornalisti di visitare la Cina sperimentale reattore veloce in Cina Istituto di energia atomica (CIAE) della China National Nuclear Corporation Xinzhen nella città di Pechino, capitale della Cina, 18 aprile 2019. CIAE è il luogo di nascita di della Cina di tecnologia nucleare. (Xinhua/Cai Yang)

RMKT2K3T–Questo affiche, o manifesto, dell'Organizzazione Mondiale della Sanità (OMS) e dell'Agenzia Internazionale per l'energia atomica (AIEA) è un'opera di sensibilizzazione sanitaria e nucleare, volta a informare il pubblico sul ruolo della tecnologia nucleare nell'assistenza sanitaria.

RMHA6RRR–L’iniziativa del Los Alamos National Laboratory di applicare la tecnologia nucleare per il trattamento del cancro rappresenta un cambiamento rivoluzionario nell’applicazione della ricerca scientifica avanzata per uso medico.

RM2APJK76–Dimostrazione contro i getti atomici ad Amsterdam; dimostrazione sommaria Data: 25 gennaio 1975 luogo: Amsterdam, Noord-Holland Parole Chiave: Dimostrazioni

RM2K5DPHP–Sarah Yee partecipa alla conferenza NETS 2022 a Cleveland, dove vengono presentati e discussi gli sviluppi della tecnologia nucleare per la propulsione spaziale, i sistemi energetici e i materiali.
RF2S7731W–Scienza e tecnologia 25 pacchetto icone FilledLine con radioattività inclusa. radiazione nucleare. blocco note. tecnologia. molecola

RM2CC963X–La centrale nucleare Neckarwestheim è in funzione dal 1976 con l'unità uno. Il generatore è il più grande generatore CA monofase al mondo.

RF2A79D4Y–Energia di atomo di simbolo sul palazzo di vetro. In mirroring e sky city sulla facciata moderna. La scienza, la tecnologia e l'industria nucleare concetto di centro 3D renderi

RM2JRARJ0–Ex centrale nucleare sperimentale del Lago di Brasimone (Bologna, Italia), attualmente convertita dall'ENEA (Agenzia Nazionale per le nuove tecnologie, energia e atmosfera) in un centro di ricerca per lo sviluppo di tecnologie di fusione termonucleare controllata, l'innovazione dei sistemi nucleari e il monitoraggio ambientale.

RF3CYKEMP–La centrale nucleare di Rooppur è il primo progetto di energia nucleare del Bangladesh, costruito per soddisfare la crescente domanda di energia elettrica della nazione in modo sostenibile.

RF3B3XBEG–Primo piano di uno smartphone che visualizza l'intelligenza artificiale composta da personaggi in stile chatbot, con una centrale nucleare leggermente sfocata sullo sfondo

RMHX3D00–Due partecipanti prendono parte a una medicina nucleare corso di tecnologia presentata dalla speciale Divisione Formazione di Oak Ridge università associate, 1970. Immagine cortesia del Dipartimento Americano di Energia.

RMT5KYWW–(190425) -- Pechino, 25 aprile 2019 (Xinhua) -- un membro del personale introduce una struttura presso l'istituto cinese di energia atomica (CIAE) della China National Nuclear Corporation Xinzhen nella città di Pechino, capitale della Cina, 17 aprile 2019. CIAE è il luogo di nascita di della Cina di tecnologia nucleare. (Xinhua/Cai Yang)

RM2RRKBF0–220829 -- TEHERAN, 29 agosto 2022 -- il presidente iraniano Ebrahim Raisi parla a una conferenza stampa a Teheran, Iran, il 29 agosto 2022. Raisi ha detto lunedì l'Iran non ha cercato di sviluppare armi nucleari, ma avrebbe impiegato tecnologia nucleare per scopi civili. /Handout via Xinhua IRAN-TEHERAN-PRESIDENT-PRESS CONFERENCE IranianxPresidentialxWebsite PUBLICATIONxNOTxINxCHN

RM2MCATW8–220628-N-AL206-1024 NORFOLK, VIRGINIA (28 giugno 2022) – Troy J. Mueller, direttore della Divisione tecnologia nucleare, reattori navali, si rivolge ai partecipanti al Commander, Naval Air Forces Safety Summit, 28 giugno. Il Safety Summit è uno strumento di implementazione per la strategia “Get Real, Get Better” attraverso un’auto-valutazione onesta, una mentalità di apprendimento e una ricerca incessante di miglioramento. Una cultura di “Get Real, Get Better” non solo rende le organizzazioni più efficienti, ma identifica e mitiga in modo aggressivo il rischio di mantenere le persone, le navi e gli aerei in lotta e di consentire la preparazione alle guerre.

RMKT5C5W–L'impianto di produzione e ricerca di Oak Ridge nel Tennessee è un sito chiave per la ricerca scientifica e la tecnologia nucleare. Ha svolto un ruolo significativo nello sviluppo dell'energia nucleare e delle armi durante il XX secolo.

RMHA6TJF–Il Los Alamos National Laboratory Archives and History Program conserva documenti storici chiave e fotografie relative allo sviluppo della tecnologia nucleare. Il programma offre una panoramica completa dei contributi del laboratorio alla scienza e alla storia.

RM2K5EW81–Il Dr. Bhavya Lal, associate Administrator for Technology, partecipa alla conferenza NETS 2022 per discutere le innovazioni della tecnologia nucleare per le missioni spaziali con i partecipanti agli eventi e gli esperti.

RM2XD410A–Hasselt University Educational Head of Nuclear Technology Wouter Schroeyers, Hasselt University Vice Rettore Education Wanda Guedens, Norwegian University of Life Sciences Rector Siri Fjellheim e Norwegian University of Life Sciences Faculty Dean Ågot Aakra, nella foto della cerimonia di firma tra imprese belghe e norvegesi, parte di una missione economica in Norvegia, mercoledì 19 giugno 2024. La principessa belga sta guidando una delegazione belga per discutere la transizione energetica, l'economia circolare, le scienze della vita e il design nei prossimi quattro giorni. BELGA FOTO BENOIT DOPPAGNE
RF2S7NHH4–piccolo reattore nucleare modulare, tecnologia del futuro, vettore di icone a colori. piccolo reattore nucleare modulare, simbolo tecnologico del futuro. illustrazione del simbolo isolato. illustrazione vettoriale dell'icona a colori del reattore nucleare modulare di piccole dimensioni con tecnologia futura

RMB524MD–Il dominio della macina Centrale Nucleare, Waterford, Connecticut USA, il più grande impianto di energia nucleare nel New England e la sola nel Connecticut.

RMG4RB4C–Con Allday, presidente della British Nuclear Fuels (BNF) presso la centrale nucleare di Sellafield a Cumbria, con il direttore della centrale Roy Pilling (Right), dove ha parlato recentemente dello scarico di materiale radioattivo nel Mare d'Irlanda.

RM2RHG85R–Austin Texas USA, 16 agosto 2023: JIM FITTERLING, presidente e CEO di Dow Chemical, parla dell'importanza dello sviluppo della tecnologia nucleare e dell'energia in Texas. Il piano è incentrato su piccoli reattori modulari (SMR) di capacità di 80 megawatt che, in gruppi, alimenterebbero le esigenze delle grandi raffinerie chimiche del Texas lungo la costa del Texas. ©Bob Daemmrich

RF2A79D5F–Energia di atomo di simbolo sul palazzo di vetro. In mirroring e sky city sulla facciata moderna. La scienza, la tecnologia e l'industria nucleare concetto di centro 3D renderi

RM2JRARJT–Ex centrale nucleare sperimentale del Lago di Brasimone (Bologna, Italia), attualmente convertita dall'ENEA (Agenzia Nazionale per le nuove tecnologie, energia e atmosfera) in un centro di ricerca per lo sviluppo di tecnologie di fusione termonucleare controllata, l'innovazione dei sistemi nucleari e il monitoraggio ambientale.

RF3CYKEMC–La centrale nucleare di Rooppur è il primo progetto di energia nucleare del Bangladesh, costruito per soddisfare la crescente domanda di energia elettrica della nazione in modo sostenibile.

RMHX3CKD–I partecipanti in uno della medicina nucleare corsi di tecnologia presentati regolarmente dalla speciale Training Division di Oak Ridge università associate, Oak Ridge, Tennessee, 1970. Immagine cortesia del Dipartimento Americano di Energia.

RF2RR8AAR–Biologia molecolare natura tecnologia nucleare rispettosa dell'ambiente con concetto Leaves di fisica della scienza verde

RMT5KYWT–(190425) -- Pechino, 25 aprile 2019 (Xinhua) -- giornalisti visita una miniatura fonte di neutroni reattore (MNSR) alla Cina Istituto di energia atomica (CIAE) della China National Nuclear Corporation Xinzhen nella città di Pechino, capitale della Cina, 18 aprile 2019. CIAE è il luogo di nascita di della Cina di tecnologia nucleare. (Xinhua/Cai Yang)

RF2T8AYEN–Una rappresentazione digitale di una bobina energetica quantistica, che simboleggia concetti energetici avanzati, da quelli convenzionali a quelli nucleari e teorici di energia libera.

RMKJ3C40–Questa immagine raffigura il pool di reattori PRR-1, un primo reattore nucleare sperimentale utilizzato per la ricerca e lo sviluppo nella metà del XX secolo. Il reattore è stato uno dei primi nella sua categoria, contribuendo ai progressi della tecnologia nucleare.

RMHA6RPD–Questa immagine ripercorre la storia del processo Trinity to Trinity al Los Alamos National Laboratory, una parte fondamentale dello sviluppo della tecnologia nucleare nel XX secolo. Essa mette in evidenza eventi significativi del periodo 1959-1991.

RM2K5DN90–Il Dr. Bhavya Lal partecipa alla conferenza NETS 2022, partecipando a discussioni sulle applicazioni della tecnologia nucleare per le missioni spaziali e i programmi di ricerca con altri professionisti.

RFHN2Y3X–Vista della centrale nucleare in Spagna. Castilla la Mancha, Guadalajara. Il fumo' uscente di torri di raffreddamento è vapore acqueo
RF2S7NCXD–piccolo reattore nucleare modulare, tecnologia del futuro, vettore isometrico a icone. piccolo reattore nucleare modulare, simbolo tecnologico del futuro. illustrazione del simbolo isolato. illustrazione del vettore isometrico a icone della tecnologia del futuro del reattore nucleare modulare di piccole dimensioni

RMB5254K–Il dominio della macina Centrale Nucleare, Waterford, Connecticut USA, il più grande impianto di energia nucleare nel New England e la sola nel Connecticut.

RMG45X49–Condotte provenienti dalla centrale nucleare Windscale, che trasportano effluenti mediamente attivi dopo il trattamento per lo scarico in mare.

RM2RHG85P–Austin Texas USA, 16 agosto 2023: JIM FITTERLING, presidente e CEO di Dow Chemical, parla dell'importanza dello sviluppo della tecnologia nucleare e dell'energia in Texas. Il piano è incentrato su piccoli reattori modulari (SMR) di capacità di 80 megawatt che, in gruppi, alimenterebbero le esigenze delle grandi raffinerie chimiche del Texas lungo la costa del Texas. ©Bob Daemmrich

RF2A79D5N–Energia di atomo di simbolo sul palazzo di vetro. In mirroring e sky city sulla facciata moderna. La scienza, la tecnologia e l'industria nucleare concetto di centro 3D renderi

RM2JRARKP–Ex centrale nucleare sperimentale del Lago di Brasimone (Bologna, Italia), attualmente convertita dall'ENEA (Agenzia Nazionale per le nuove tecnologie, energia e atmosfera) in un centro di ricerca per lo sviluppo di tecnologie di fusione termonucleare controllata, l'innovazione dei sistemi nucleari e il monitoraggio ambientale.

RM3BCGPR7–Germania - 3 agosto 2020: Vista della centrale nucleare di Grohnde a Emmerthal, bassa Sassonia

RF3CYKEMF–La centrale nucleare di Rooppur è il primo progetto di energia nucleare del Bangladesh, costruito per soddisfare la crescente domanda di energia elettrica della nazione in modo sostenibile.

RFC4F9GT–Una centrale nucleare su sabbia enorme di vetro con rifiuti atomica all'interno dalla parte superiore

RMHX3DFT–Saldatura a fascio di elettroni, sviluppate principalmente per la fabbricazione di elementi combustibili nucleari, è stata adattata per l'uso in tutte le aree di saldatura industriale, Richland, Washington, 1966. Immagine cortesia del Dipartimento Americano di Energia.

RMD40MRE–Lavorando con avvisatore acustico la tecnologia di localizzazione sul sommergibile nucleare HMS Talento, Egitto

RMT5KYX4–(190425) -- Pechino, 25 aprile 2019 (Xinhua) -- Zhang Tianjue, chief esperto della China National Nuclear Corporation, introduce il primo ciclotrone della Cina in Cina Istituto di energia atomica (CIAE) Xinzhen nella città di Pechino, capitale della Cina, Aprile 16, 2019. CIAE è il luogo di nascita di della Cina di tecnologia nucleare. (Xinhua/Cai Yang)

RM2XTD03H–Moskau, Russia. 4 agosto 2024. I visitatori possono ammirare varie mostre in una sala. Il nuovo Museo atomico russo fornisce informazioni sugli inizi dell'uso della tecnologia nucleare fino al presente e al futuro. (A dpa "spionaggio, bombe, scienza - la Russia celebra l'energia nucleare") credito: Ulf Mauder/dpa/Alamy Live News

RMKT0C8R–"AtomicWar0214" si riferisce a una rappresentazione visiva o artistica relativa al tema della guerra atomica o al concetto di conflitto nucleare. L'opera d'arte o l'immagine enfatizza le gravi implicazioni dell'energia atomica e della guerra, probabilmente riflettendo eventi storici o timori associati alla tecnologia nucleare.
RMHA6RRH–La Mold Rush è stato un progetto critico presso il Los Alamos National Laboratory relativo allo sviluppo della tecnologia nucleare durante la seconda guerra mondiale. L'immagine documenta il lavoro in questo sito fondamentale, che ha svolto un ruolo importante nel progetto Manhattan.

RM2AW6B51–Panoramica Mostra Atom Dam Amsterdam Data: 21 Febbraio 1955 Località: Amsterdam, Noord-Holland Parole Chiave: Grafici

RM2K5EG10–I partecipanti alla conferenza Nuclear Emerging Technologies for Space (NETS) 2022 si sono riuniti al Westin Cleveland Downtown, tra cui James Reuter, amministratore associato del Space Technology Mission Directorate della NASA, per discutere i progressi nella tecnologia nucleare per le applicazioni spaziali.




















